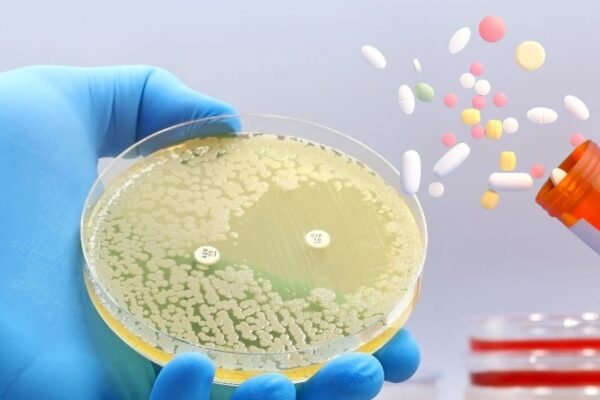

এই ঔষধি গুঁড়োর রয়েছে আশ্চর্যজনক উপকারিতা, এটি অনেক রোগের প্রতিষেধক, এভাবে ব্যবহার করুন।
এক্স এই ঔষধি পাউডারের আশ্চর্যজনক উপকারিতা রয়েছে, এটি অনেক রোগের জন্য একটি নিরাময়। স্বাস্থ্য টিপস: ত্রিফলা গুঁড়োকে পলি হারবালও বলা হয়। এর মধ্যে রয়েছে আমলা, বহেদা এবং হাদ্রা (হরিতকি)। কার্বোহাইড্রেট ছাড়াও এতে ভিটামিন, মিনারেল, সোডিয়াম, ডায়েটারি ফাইবার, শক্তিশালী অ্যান্টিঅক্সিডেন্ট গ্যালিক অ্যাসিড এবং চেবুলিক অ্যাসিড পাওয়া যায়। ডাক্তারের মতে, ত্রিফলা খাবারের সঠিক হজম এবং শোষণকেও উন্নীত…